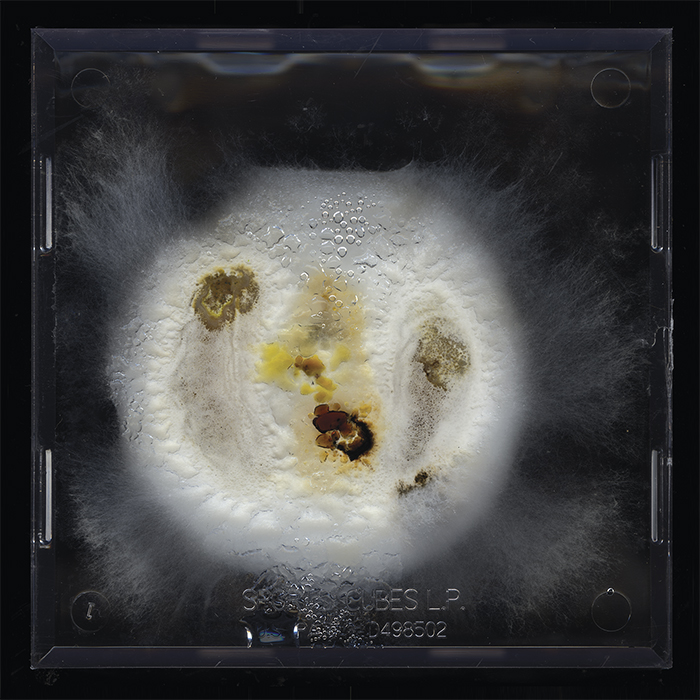
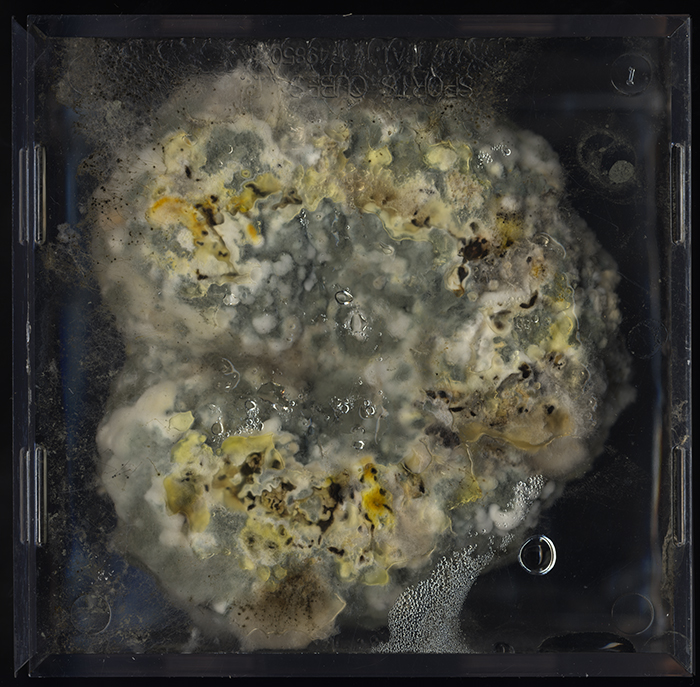

Digital Photography
Samsara means the eternal cycle of birth, suffering, death, and rebirth.
This is an analogy between a decaying fruit enclosed in a cube and a dead body in a coffin. I see a similar vitality and an eternal cycle. There is dying and decaying, but at the same time, new lives are gradually growing. They even will become dust and water to nourish and build more lives in the world. Dust to dust, soil-to-soil, life to death, death to life, and in this way, there is no end of birth, suffering, death and rebirth.